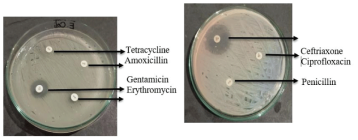
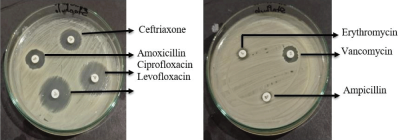

Abstract
Research Article
Identification, Molecular Confirmation, and Antibiotic Sensitivity of Bacteria Isolated from Repeat Breeder Cows in Rangpur Division
Mst. Mousumi Afroj, Md Faruk Islam, Muhammad Mamunur Roshid, Md Shanto Hossain, Md Samiul Tousif, Omiaya Azam Oishi, Subroto Sarma and Begum Fatema Zohara*
Published: 10 October, 2025 | Volume 9 - Issue 1 | Pages: 008-17
Aims: The study was conducted from January to June 2023 to observe the prevalence of repeat breeding syndrome in cows, to isolate and identify the bacteria with their molecular confirmation, and antibiotic sensitivity in Bangladesh.
Study design & Place and duration of study: The study was conducted under the supervision of the Department of Medicine, Surgery, and Obstetrics, Hajee Mohammad Danesh Science and Technology University, Dinajpur-5200. Some laboratory work was performed at the Microbiology Department of Pathology and Parasitology laboratory, HSTU, from January to June 2023.
Methodology: A questionnaire was used to identify repeat breeding syndrome. Bacteria were isolated and identified from the cervical mucus of affected cows. For confirmation of the detected bacteria, PCR was used. The agar disc diffusion method was utilized to investigate the antibiotic sensitivity of the detected isolates against widely used antibiotics in vitro.
Results: The prevalence of Repeat Breeding (RB) was 41.33%. The prevalence of E. coli was 40%, Staphylococcus aureus 40% and Klebsiella spp. 10%. Molecular detection of E. coli and Staphylococcus aureus was confirmed by using Eco 223 (F), Eco 455 (R), Sau 234(F), and Sau 1501(R) primers. The target genes were 16S and 23S rRNA, and the size of the product amplified at 232 bp and 1267 bp, respectively. According to the antibiogram profile, E. coli was resistant to ciprofloxacin, penicillin, tetracycline, amoxicillin, and erythromycin, but sensitive to ceftriaxone and gentamicin. While Staphylococcus aureus was resistant to ampicillin and erythromycin, it was sensitive to ciprofloxacin, ceftriaxone, and levofloxacin. It was also intermediately resistant to vancomycin and amoxicillin. Klebsiella spp. Showed resistance to ceftriaxone, penicillin, and amoxicillin, while remaining sensitive to ciprofloxacin, tetracycline, and intermediate resistance to erythromycin and gentamicin.
Conclusion: This study concluded that E. coli, Staphylococcus aureus, and Klebsiella spp. are the most common bacteria causing repeat breeding syndrome in cows.
Read Full Article HTML DOI: 10.29328/journal.ivs.1001047 Cite this Article Read Full Article PDF
Keywords:
Antibiotic sensitivity; Bacteria; Molecular confirmation; PCR; Repeat breeding
References
- Livestock Economy at a Glance (2024–2025). Available from: https://dls.portal.gov.bd/sites/default/files/files/dls.portal.gov.bd/page/ee5f4621_fa3a_40ac_8bd9_898fb8ee4700/2025-07-20-09-46-679bbf1e9a6f6095c509ad08338a61f7.pdf
- Yadav JC. Identification and characterization of uterine bacteria and selection of treatment strategy in repeat breeding cows to increase conception rate in dairy farms in Chattogram. 2020. Available from: https://123dok.com/bd/docs/microorganisms-selection-treatment-strategy-repeat-breeding-increase-conception.10808577
- Tanimura K, Uematsu M, Kitahara G, Osawa T, Sasaki Y. Longitudinal effect of repeat breeding in Japanese Black beef cattle at a low parity on subsequent fertility in commercial cow–calf operations. Theriogenology. 2022;189:177–82. Available from: https://doi.org/10.1016/j.theriogenology.2022.05.016
- Islam MS, Deb GK, Nurunnahar T, Ershaduzzaman M, Habib MA, Ali MY, et al. Identification of possible causes of repeat breeding in dairy cows at Baghabari milk shed areas, Sirajgonj, Bangladesh. Asian J Med Biol Res. 2017;3(2):186–90. Available from: https://www.banglajol.info/index.php/AJMBR/article/view/33567
- Matubber B, Paul A, Das S. Evaluation of different parameters in relation to repeat breeding of cows in the coastal areas of Bangladesh. Res Agric Livest Fish. 2018;5(1):49. Available from: https://doi.org/10.3329/ralf.v5i1.36552
- Islam MN, Habib MR, Khandakar MM, Rashid MH, Sarker MA, Bari MS, et al. Repeat breeding: prevalence and potential causes in dairy cows at different milk pocket areas of Bangladesh. Trop Anim Health Prod. 2023;55(2):120. Available from: https://doi.org/10.1007/s11250-023-03537-z
- Perez-Marin CC, Quintela LA. Current insights into the repeat breeder cow syndrome. Animals (Basel). 2023;13:2187. Available from: https://doi.org/10.3390/ani13132187
- Pérez-Marin CC, Moreno LM, Calero GV. Clinical approach to the repeat breeder cow syndrome. In: A bird's-eye view of veterinary medicine. 2012:337–62. Available from: https://www.intechopen.com/chapters/28681
- Ali S. Fertilization failure and early embryonic mortality as a major cause of reproductive failure in cattle: a review. 2021;34:59–71. Available from: https://www.researchgate.net/publication/356163828_Fertilization_failure_and_early_embryonic_mortality_as_a_major_cause_of_reproductive_failure_in_cattle_A_review
- Thasmi CN, Husnurrizal H, Wahyuni S, Hafizuddin H, Siregar TN. Identification of bacteria in Aceh cattle with repeat breeding. Vet ir Zootech. 2021;79(2):32–6. Available from: https://www.researchgate.net/publication/358595998_Identification_of_Bacteria_in_Aceh_Cattle_with_Repeat_Breeding
- Preeti A, Reddy PKN, Anand, Patil A, Rajeshwari. Repeat breeding in bovines: a review. Pharma Innov J. 2023;12(9):2105–12. Available from: https://www.thepharmajournal.com/archives/2023/vol12issue9S/PartAB/S-12-9-196-862.pdf
- Carbonari A, Burgio M, Frattina L, Cicirelli V, Rizzo A. Repeat breeder syndrome therapies in dairy cows: a review. Reprod Domest Anim. 2024;59(10):e14732. Available from: https://doi.org/10.1111/rda.14732
- Sood P, Zachut M, Dube H, Moallem U. Behavioral and hormonal pattern of repeat breeder cows around estrus. Reproduction. 2015;149(6):545–54. Available from: https://doi.org/10.1530/rep-14-0598
- Singh M, Kapoor S, Sharma S, et al. Studies on the clinical efficacy of ciprofloxacin administered through the intrauterine route in repeat breeder cows suffering from endometritis in Himachal Pradesh. Intas Polivet. 2004;5:209–10. Available from: https://www.cabidigitallibrary.org/doi/pdf/10.5555/20053131300
- Bayot ML, Bragg BN. Antimicrobial susceptibility testing. In: StatPearls [Internet]. Treasure Island (FL): StatPearls Publishing; 2025. Updated 2024 May 27. Available from: https://pubmed.ncbi.nlm.nih.gov/30969536/
- Riffon R, Sayasith K, Khalil H, Dubreuil P, Drolet M, Lagacé J. Development of a rapid and sensitive test for identification of major pathogens in bovine mastitis by PCR. J Clin Microbiol. 2001;39(7):2584–9. Available from: https://doi.org/10.1128/jcm.39.7.2584-2589.2001
- Tanimura K, Uematsu M, Kitahara G, Osawa T, Sasaki Y. Longitudinal effect of repeat breeding in Japanese Black beef cattle at a low parity on subsequent fertility in commercial cow–calf operations. Theriogenology. 2022;189:177–82. Available from: https://doi.org/10.1016/j.theriogenology.2022.05.016
- Asaduzzaman KM, Bhuiyan MM, Rahman MM, Bhattacharjee J. Prevalence of repeat breeding and its effective treatment in cows at selected areas of Bangladesh. Bangl J Vet Med. 2016;14(2):183–90. Available from: https://doi.org/10.3329/bjvm.v14i2.31391
- Mekonnin AB, Harlow CR, Gidey G, Tadesse D, Desta G, et al. Assessment of reproductive performance and problems in crossbred (Holstein Friesian × Zebu) dairy cattle in and around Mekelle, Tigray, Ethiopia. Anim Vet Sci. 2015;3(3):94–101. Available from: https://doi.org/10.11648/j.avs.20150303.14
- Mandefro MM, Negash GN. Repeat breeder syndrome in dairy cows: influence of breed and age on its prevalence. 2014;10(4):200–203. Available from: https://www.idosi.org/wjas/wjas10(4)14/8.pdf
- Adane H, Yisehak T, Niguse T. Assessment of major reproductive disorders of dairy cattle in the urban and peri-urban area of Hosanna, Southern Ethiopia. J Anim Vet Sci. 2014;2(5):135–41. Available from: https://doi.org/10.11648/j.avs.20140205.11
- Maruf AA, Islam MR, Rahman MM, Bhuiyan MMU, Shamsuddin M. Prevalence of reproductive disorders of dairy cows in Chittagong District of Bangladesh. Bangladesh Vet J. 2012;46(1–4):11–18. Available from: https://www.researchgate.net/publication/303033917_Prevalence_of_reproductive_disorders_of_dairy_cows_in_Chittagong_district_of_Bangladesh
- Bitew M, Prasad S. Study on major reproductive health problems in indigenous and cross-breed cows in and around Bedelle, South West Ethiopia. J Anim Vet Adv. 2011;10:723–7. Available from: https://doi.org/10.3923/javaa.2011.723.727
- Gani MO, Amin MM, Alam MG, Kayesh ME, Karim MR, Samad MA, et al. Bacterial flora associated with repeat breeding and uterine infections in dairy cows. Bangl J Vet Med. 2008;6(1):79–86. Available from: https://www.banglajol.info/index.php/BJVM/article/view/1342
- Cheesbrough M. District laboratory practice in tropical countries, part 2. Cambridge: Cambridge University Press; 2005. Available from: https://www.scirp.org/reference/referencespapers?referenceid=2090202
- Luepke KH, Mohr JF 3rd. The antibiotic pipeline: reviving research and development and speeding drugs to market. Expert Rev Anti Infect Ther. 2017 May 4;15(5):425–33. Available from: https://doi.org/10.1080/14787210.2017.1308251
- Spellberg B, Powers JH, Brass EP, Miller LG, Edwards JE Jr. Trends in antimicrobial drug development: implications for the future. Clin Infect Dis. 2004;38(9):1279–86. Available from: https://doi.org/10.1086/420937
- Ayukekbong JA, Ntemgwa M, Atabe AN. The threat of antimicrobial resistance in developing countries: causes and control strategies. Antimicrob Resist Infect Control. 2017 May 15;6:47. Available from: https://doi.org/10.1186/s13756-017-0208-x
- Sosa A, Byarugaba DK, Amabile C, Hsueh PR, Kariuki S, Okeke IN. Antimicrobial resistance in developing countries. Microbiology. 2010. Available from: https://doi.org/10.1007/978-0-387-89370-9
- Rahman MA, Alam MG, Shamsuddin M, Rahman MM. Antibiotic sensitivity of the bacteria isolated from endometrial biopsies of cows.
- Asna SM, Haq JA, Rahman MM. Nalidixic acid-resistant Salmonella enterica serovar Typhi with decreased susceptibility to ciprofloxacin caused treatment failure: a report from Bangladesh. Jpn J Infect Dis. 2003;56(1):32–3. Available from: https://pubmed.ncbi.nlm.nih.gov/12711825/
- Biswas M, Roy DN, Tajmim A, Rajib SS, Hossain M, Farzana F, Yasmen N. Prescription antibiotics for outpatients in Bangladesh: a cross-sectional health survey conducted in three cities. Ann Clin Microbiol Antimicrob. 2014;13:15. Available from: https://doi.org/10.1186/1476-0711-13-15
- Sutradhar KB, Saha A, Huda NH, Uddin R. Irrational use of antibiotics and antibiotic resistance in southern rural Bangladesh: perspectives from both the physicians and patients. Annu Res Rev Biol. 2014;4(9):1421. Available from: https://doi.org/10.9734/ARRB/2014/8184
- Moges N, Regassa F, Yilma T, Unakal CG. Isolation and antimicrobial susceptibility of bacteria from dairy cows with clinical endometritis. J Reprod Infertil. 2013;4(1):4–8. Available from: https://www.researchgate.net/publication/259397697_Isolation_and_Antimicrobial_Susceptibility_of_Bacteria_from_Dairy_Cows_with_Clinical_Endometritis
- Liu J, Enzelberger M, Quake S. A nanoliter rotary device for polymerase chain reaction. Electrophoresis. 2002;23(10):1531–6. Available from: https://doi.org/10.1002/1522-2683(200205)23:10%3C1531::aid-elps1531%3E3.0.co;2-d
- Bes M, Guérin-Faublée V, Meugnier H, Etienne J, Freney J. Improvement of the identification of staphylococci isolated from bovine mammary infections using molecular methods. Vet Microbiol. 2000;71(3–4):287–94. Available from: https://doi.org/10.1016/s0378-1135(99)00163-7
- Whitehead TR, Cotta MA. Development of molecular methods for the identification of Streptococcus bovis from human and ruminal origins. FEMS Microbiol Lett. 2000;182(2):237–40. Available from: https://doi.org/10.1111/j.1574-6968.2000.tb08901.x
Figures:

Figure 1

Figure 2

Figure 3
Figure 4
Figure 5

Figure 6

Figure 7

Figure 8
Similar Articles
-
Efficacies of 11% Lactoferricin and 0.05% Chlorhexidine Otological Solution compared, in the treatment of microbial otic overgrowth: A randomized single blinded studyLuisa Cornegliani*,Federico Leone,Francesco Albanese,Mauro Bigliati,Natalia Fanton,Antonella Vercelli. Efficacies of 11% Lactoferricin and 0.05% Chlorhexidine Otological Solution compared, in the treatment of microbial otic overgrowth: A randomized single blinded study. . 2017 doi: 10.29328/journal.ivs.1001004; 1: 032-041
-
In vitro antimicrobial activity of a black currant oil based shampoo versus a chlorhexidine 4% shampoo on bacteria strains isolated from canine pyoderma: A comparative studyAntonio Corona*,Paola Persico,Antonella Vercelli,Alessandro Gramenzi,Luisa Cornegliani. In vitro antimicrobial activity of a black currant oil based shampoo versus a chlorhexidine 4% shampoo on bacteria strains isolated from canine pyoderma: A comparative study. . 2020 doi: 10.29328/journal.ivs.1001021; 4: 014-017
-
Myiasis in a Backyard Pig: A Case ReportMd Niamot Ali, Mahdi Hasan, Ireen Sultana Shanta, Md Abu Choudhury, Mustafizur Rahman, Abdulla Al Mamun Bhuyan*. Myiasis in a Backyard Pig: A Case Report. . 2024 doi: 10.29328/journal.ivs.1001042; 8: 015-017
-
Intrauterine Therapy with Platelet-Rich Plasma for Persistent Breeding-Induced Endometritis in Mares: A ReviewThiago Magalhães Resende*,Renata Albuquerque de Pino Maranhão,Ana Luisa Soares de Miranda,Lorenzo GTM Segabinazzi,Priscila Fantini. Intrauterine Therapy with Platelet-Rich Plasma for Persistent Breeding-Induced Endometritis in Mares: A Review. . 2024 doi: 10.29328/journal.ivs.1001045; 8: 039-047
-
Identification, Molecular Confirmation, and Antibiotic Sensitivity of Bacteria Isolated from Repeat Breeder Cows in Rangpur DivisionMst. Mousumi Afroj,Md Faruk Islam,Muhammad Mamunur Roshid,Md Shanto Hossain,Md Samiul Tousif,Omiaya Azam Oishi,Subroto Sarma,Begum Fatema Zohara*. Identification, Molecular Confirmation, and Antibiotic Sensitivity of Bacteria Isolated from Repeat Breeder Cows in Rangpur Division. . 2025 doi: 10.29328/journal.ivs.1001047; 9: 008-17
Recently Viewed
-
Sustainable Weight Loss and Body Composition Improvement through Intensive Lifestyle Modification with Meal Replacement: A 12-Case Series with International PerspectivesNawinda Vanichakulthada*,Sunaree Pitchaiprasert,Rasintra Jaroenying,Sumalee Hantragool,Chutima Samhugkanee. Sustainable Weight Loss and Body Composition Improvement through Intensive Lifestyle Modification with Meal Replacement: A 12-Case Series with International Perspectives. Ann Clin Endocrinol Metabol. 2026: doi: 10.29328/journal.acem.1001034; 10: 17-25
-
Human Poxvirus Infections: Epidemiology, Transmission, and Clinical Features of Major Orthopoxvirus DiseasesTrisha Chakraborty,Naima Siddiqua,Subrin Shabab Trisa,Syeda Fatima Anwar,Gazi Wafa Akbar*. Human Poxvirus Infections: Epidemiology, Transmission, and Clinical Features of Major Orthopoxvirus Diseases. Int J Clin Microbiol Biochem Technol. 2026: doi: 10.29328/journal.ijcmbt.1001038; 9: 34-39
-
SARS-CoV-2 antibody response to third dose vaccination in a healthy cohortSimmi Patel*,Sarah E Wheeler,Adam Anderson,Lisa Pinto,Michael R Shurin. SARS-CoV-2 antibody response to third dose vaccination in a healthy cohort. Insights Clin Cell Immunol. 2022: doi: 10.29328/journal.icci.1001020; 6: 008-013
-
Foam Sclerotherapy versus surgery in treatment of chronic venous diseaseFatih Islamoglu*. Foam Sclerotherapy versus surgery in treatment of chronic venous disease. Arch Vas Med. 2020: doi: 10.29328/journal.avm.1001011; 4: 005-007
-
Atypical manifestations of pulmonary embolismOscar MP Jolobe*. Atypical manifestations of pulmonary embolism. Arch Vas Med. 2020: doi: 10.29328/journal.avm.1001012; 4: 008-018
Most Viewed
-
Physical Performance in the Overweight/Obesity Children Evaluation and RehabilitationCristina Popescu, Mircea-Sebastian Șerbănescu, Gigi Calin*, Magdalena Rodica Trăistaru. Physical Performance in the Overweight/Obesity Children Evaluation and Rehabilitation. Ann Clin Endocrinol Metabol. 2024 doi: 10.29328/journal.acem.1001030; 8: 004-012
-
Hypercalcaemic Crisis Associated with Hyperthyroidism: A Rare and Challenging PresentationKarthik Baburaj*, Priya Thottiyil Nair, Abeed Hussain, Vimal MV. Hypercalcaemic Crisis Associated with Hyperthyroidism: A Rare and Challenging Presentation. Ann Clin Endocrinol Metabol. 2024 doi: 10.29328/journal.acem.1001029; 8: 001-003
-
Effects of dietary supplementation on progression to type 2 diabetes in subjects with prediabetes: a single center randomized double-blind placebo-controlled trialSathit Niramitmahapanya*,Preeyapat Chattieng,Tiersidh Nasomphan,Korbtham Sathirakul. Effects of dietary supplementation on progression to type 2 diabetes in subjects with prediabetes: a single center randomized double-blind placebo-controlled trial. Ann Clin Endocrinol Metabol. 2023 doi: 10.29328/journal.acem.1001026; 7: 00-007
-
Exceptional cancer responders: A zone-to-goDaniel Gandia,Cecilia Suárez*. Exceptional cancer responders: A zone-to-go. Arch Cancer Sci Ther. 2023 doi: 10.29328/journal.acst.1001033; 7: 001-002
-
Ectopic adrenal tissue at the spermatic cordAbdallah Chaachou,Nizar Cherni,Wael Ferjaoui*,Mohamed Dridi,Samir Ghozzi. Ectopic adrenal tissue at the spermatic cord. J Clin Med Exp Images. 2022 doi: 10.29328/journal.jcmei.1001024; 6: 001-002

If you are already a member of our network and need to keep track of any developments regarding a question you have already submitted, click "take me to my Query."
















































































































































